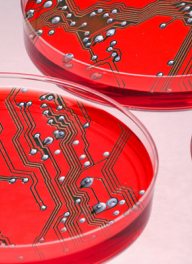

Philips Healthcare
Philips Healthcare produceert systemen voor imaging, stralingskanker, reanimatieproducten en patiëntenbewaking,
Adres
Philips Healthcare
Veenpluis 4 - 6
5684 PC BEST
Nederland
Postadres
Veenpluis 4 - 6
5684 PC BEST
Nederland

contact
Nieuws
-
Kinderen voorbereiden op MRI-onderzoeken met augmented reality
21 november 2022
-
Slimme thuismonitoring na maagverkleining verlaagt druk op ziekenhuiszorg
7 februari 2022
-
Engage maakt zorg op afstand en samenwerken in het zorgnetwerk mogelijk
22 februari 2021
-
Oplossing om coronavirus-patiënten op afstand te screenen en te volgen
22 maart 2020
-
Artificial Intelligence inzetten om operationele, klinische doelen te bereiken
16 juli 2019
-
Huisarts en cardioloog werken in één dossier voor hartfalenpatiënten
2 mei 2019
-
Thuismeting vermindert jaarlijks 3 fysieke consulten per patiënt
26 maart 2019
-
Virtueel zorgcentrum in Arnhem
11 oktober 2018
-
Draagbaar echoapparaat verovert het hart in HagaZiekenhuis
21 september 2018
-
Slimme pleister meet gezondheid
4 april 2018
-
Philips onderzoekt verband paradontitus en hart- en vaatziekten
10 april 2017